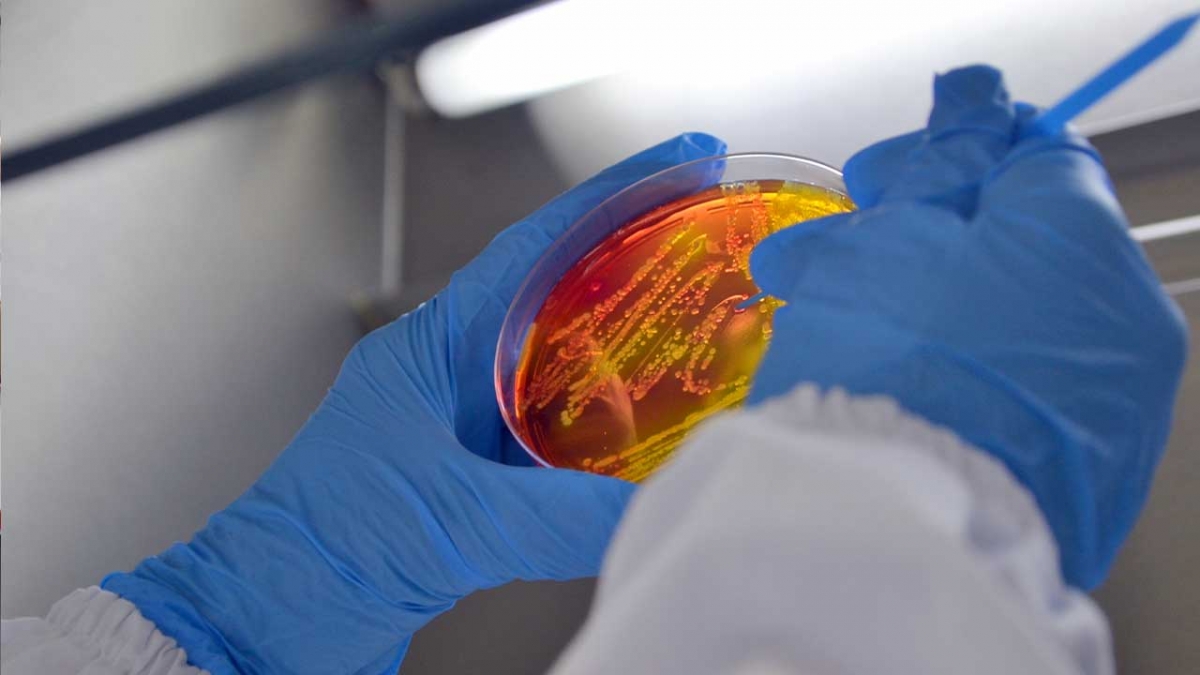

Pequenas empresas e agricultores familiares terão subsídios para realização de ensaios nos laboratórios do Iparque
As pequenas empresas e os produtores rurais de 10 municípios da região carbonífera já podem contar com subsídios para a realização de ensaios de qualidade de seus produtos. O Parque Científico e Tecnológico da Unesc (Iparque), se credenciou recentemente ao Sebraetec, um serviço realizado pelo Sebrae para conectar os pequenos negócios a uma rede de prestadores de serviço. O objetivo é promover a melhoria de processos, produtos e serviços e colaborar com a introdução de inovações nos negócios e mercados.
Por meio deste credenciamento, os agricultores familiares e proprietários de pequenas empresas irão receber do Sebraetec um subsídio de 60% para a realização de ensaios nos laboratórios do Instituto de Alimentos (Iali) e Instituto de Pesquisas Ambientais e Tecnológicas (Ipat), vinculados ao Iparque Unesc. Os outros 40% serão custeados pelo solicitante dos ensaios.
A coordenadora dos laboratórios do Ipat e Instituto de Alimentos (Iali), Josiane Ferreira Nagel, afirma que o foco dos testes será em alimentos. “Na região carbonífera temos várias atividades envolvendo alimentos como carnes, pescados, ovos, mel e produtos coloniais e por meio do Sebraetec, conseguiremos ampliar a contribuição dos laboratórios do Ipat e do Iali em auxiliar no controle de qualidade. Esses ensaios e análises com certeza irão colaborar para que tenhamos no comércio alimentos cada vez mais controlados do ponto de vista das questões de boas práticas de higiene e manipulação e com mais qualidade, dando maior segurança ao consumidor”, afirma.
Josiane chama a atenção ainda ao fato de que os ensaios e as análises serão importantes para o desenvolvimento de novos produtos, além de contribuírem com o trabalho de orientação e fiscalização dos órgãos responsáveis, como o Serviço de Inspeção Municipal (SIM), responsável em cada município por fiscalizar o setor de alimentos. Cada SIM, vinculado à respectiva prefeitura, está integrado ao Consórcio Intermunicipal Multifinalitário da Região Carbonífera (CIM-Amrec), que procura dar suporte aos serviços e articular as demandas de análises na região carbonífera.
Na região, o credenciamento ao Sebraetec vai beneficiar estabelecimentos de Criciúma, Cocal do Sul, Forquilhinha, Içara, Lauro Müller, Morro da Fumaça, Nova Veneza, Orleans, Siderópolis e Urussanga. Neste trabalho, o Iparque Unesc contará com a parceria da Epagri, que identificou 37 iniciativas que podem usufruir do subsídio para a realização de testes e análises.
A Epagri, que desenvolve o apoio técnico na assessoria das agroindústrias familiares, foi a responsável pela aproximação do Sebrae e da Unesc nesta parceria via Sebraetec, para que os empreendedores pudessem receber subsídios de 60% para a realização de análises microbiológicas dos produtos de origem animal.
Segundo o médico veterinário e coordenador do Programa de Gestão de Negócios e Mercados pela Epagri no Sul catarinense, Marcelo Silva Pedroso, a Epagri, que desenvolve o apoio técnico na assessoria das agroindústrias familiares, articulou
a parceria entre Sebrae e Unesc para o Sebratec. Ele salienta que todo o trabalho é realizado em conjunto com a Associação dos Municípios da Região Carbonífera, por meio do CIM-Amrec e que foi estabelecida uma parceria entre Unesc e Senai Chapecó para a realização das análise físico-química dos produtos.
“Estes subsídios via Sebraetec são imprescindíveis para a manutenção e desenvolvimento das agroindústrias familiares de produtos de origem animal, pois são fundamentais para a adesão do Consórcio Regional ao Sistema Brasileiro de Inspeção, o que garantirá comércio destes produtos em todo o Território Nacional”, comenta Pedroso.